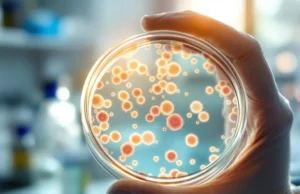
Survivre a un Cancer pourrait protéger contre Alzheimer une découverte choc

news
Perte auditive : ces signes discrets qui doivent vous alerter
Perte auditive : ces signes discrets qui doivent vous alerter
Vous vous surprenez à demander fréquemment : "Pardon, qu'est-ce que tu as dit ?" sans...
Médicaments risqués pour la mémoire des seniors découvrez lesquels éviter
Un risque accru de déclin cognitif chez les personnes âgées
Le risque de déclin cognitif lié à certains médicaments devient une préoccupation essentielle, surtout chez...
Hygiène dentaire négligée : un danger mortel qu’il faut éviter
Une mauvaise hygiène bucco-dentaire peut avoir des conséquences graves
Une hygiène dentaire négligée ne concerne pas seulement l’esthétique ou le confort. Elle peut également mettre...
Survivre a un Cancer pourrait protéger contre Alzheimer une découverte choc
Une découverte qui pourrait expliquer le lien entre cancer et Alzheimer
Depuis plusieurs années, des chercheurs ont observé un phénomène surprenant : les personnes ayant...
Froids aux pieds : découvrez comment vous réchauffer en un clin...
Avoir froid aux pieds est une sensation désagréable qui peut avoir plusieurs origines. Selon le Dr Daniel Caroff, médecin généraliste et naturopathe, cette sensation...
Alzheimer : découvrez les signes cachés avant la perte de mémoire
Alzheimer : un trouble qui dépasse la simple perte de mémoire
Selon l’Assurance Maladie, près de 710 000 personnes en France souffrent de démence. Ce...
Grippe : la campagne prolongée face à une menace toujours très...
Une circulation toujours "importante" du virus
Le gouvernement a décidé de prolonger la campagne de vaccination contre la grippe jusqu'au 28 février. La décision fait...
Se lever la nuit pour uriner : quand arrêter de boire...
Se lever la nuit pour uriner : à quel moment arrêter de boire ?
Il est courant de se retrouver la nuit face à un...
Troubles du sommeil après 50 ans : un signe d’Alzheimer en...
Démence et Alzheimer : un trouble du sommeil lié à un risque accru après 50 ans
Pour beaucoup de personnes de plus de 50 ans,...
Ce test de la main qui peut prédire votre risque de...
Un simple test de la main pour évaluer le risque de démence
La démence englobe plusieurs maladies qui provoquent une dégradation progressive de la mémoire,...